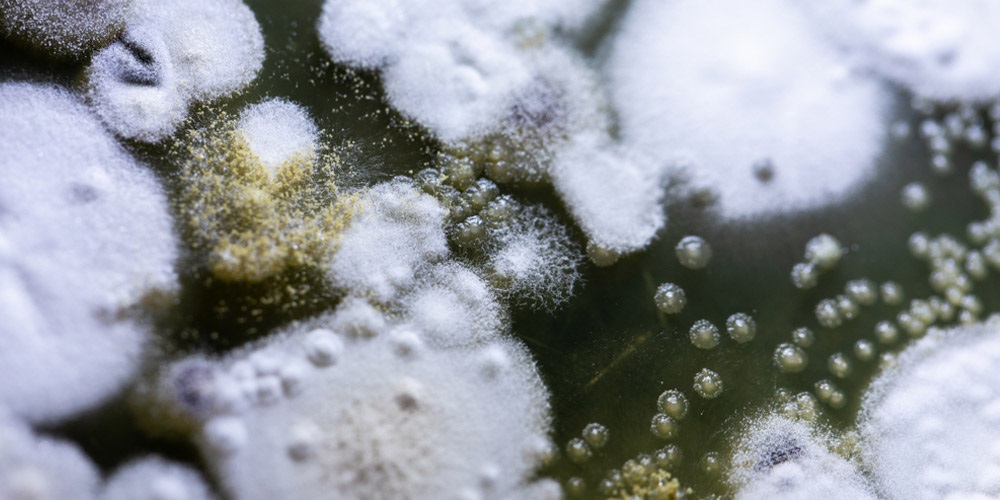
Mold and Mildew

How long can house run on Tesla Powerwall?

How Long Can House Run On Tesla Powerwall? There is no doubt that the Tesla Powerwall is one of the most innovative and ground-breaking pieces of technology on the market today. Not only is it a powerful energy storage device, but it is also perfect for homeowners in Hawaii. In this blog post, we are […]
Can I Live Off-Grid With Tesla Powerwall?

Can I Live Off-Grid With Tesla Powerwall? Many people are wondering if they can live off the grid with a Tesla Powerwall. After all, the Powerwall is known for its ability to store large amounts of energy. So, in this blog post, we’re going to answer some questions about the Powerwall and whether or not […]
How Many Powerwalls Do I Need To Go Off-Grid?

How Many Powerwalls Do I Need To Go Off-Grid? If you’re thinking about going off the grid, you’ll need to have a good understanding of your energy usage. In this blog post, we’ll provide you with a step-by-step guide on how to calculate the number of Powerwalls you need to go off the grid. We’ll […]
How Long Will It Take For Solar Panels To Pay For Themselves?

How Long Will It Take For Solar Panels To Pay For Themselves? If you’re like most people, you’re probably interested in finding ways to save money on your electric bill. And one of the best ways to do that is to install solar panels. But how long will it take for solar panels to pay […]
Is It Hard To Sell House With Solar Panels?

Is It Hard To Sell House With Solar Panels? Selling a house can be a difficult process, but solar panels can make the process much easier. In this blog post, we’ll explore the advantages and disadvantages of solar panels and how they can help you sell your home. We’ll also discuss how to increase the […]
What Type Of Roof Is Not Good For Solar Panels?

What Type Of Roof Is Not Good For Solar Panels? If you’re thinking about installing solar panels on your roof, it’s important to consider which type of roof is not good for solar panels. In this blog post, we’re going to explain the six types of roofs and which one is not good for solar […]
Does Mold Grow Under Solar Panels?
Does Mold Grow Under Solar Panels? Mold growing under solar panels is a real problem that can cause serious damage to the roof and the panels themselves. The mold, mildew, and other fungi can spread quickly, blocking the sun’s rays and reducing energy efficiency. In order to protect your investment in solar power, it’s important […]
Do You Still Have To Pay Bills If You Have Solar Panels?

Do You Still Have To Pay Bills If You Have Solar Panels? Having solar panels installed on your home can be an effective way to reduce your energy bills and become more energy-efficient. But even if you have solar panels, do you still have to pay bills? The short answer is yes – you will […]
What is the biggest problem with solar panels?

What Is The Biggest Problem With Solar Panels? Solar energy has become a popular option for many people looking to reduce their electricity bills and switch to an eco-friendly form of energy production. Despite its increasing popularity, solar panels still come with drawbacks that can be difficult to overcome. One of the biggest problems with […]
Will Solar Panels Work Through A Window?

Will Solar Panels Work Through A Window? If you’re considering installing solar panels, you may be wondering if they will work through a window. Solar panels are a great way to reduce your energy bill and help protect the environment, but they may not work through a window. In this blog post, we’re going to […]